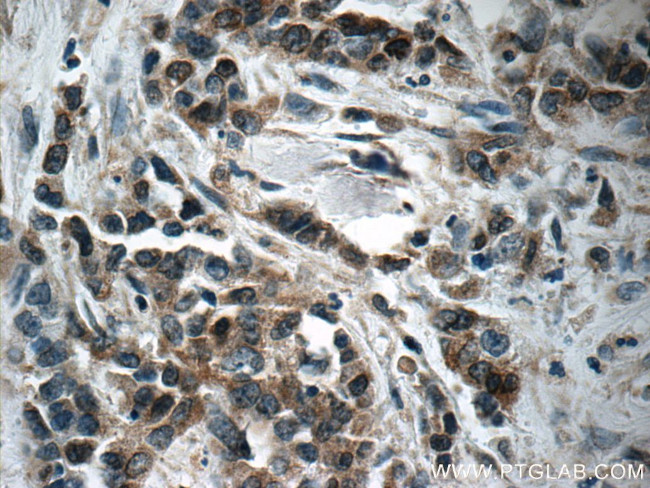
Pepsinogen I Antibody in Immunohistochemistry (Paraffin) (IHC (P))

Search
Proteintech
Pepsinogen I Polyclonal Antibody
{{$productOrderCtrl.translations['antibody.pdp.commerceCard.promotion.promotions']}}
{{$productOrderCtrl.translations['antibody.pdp.commerceCard.promotion.viewpromo']}}
{{$productOrderCtrl.translations['antibody.pdp.commerceCard.promotion.promocode']}}: {{promo.promoCode}} {{promo.promoTitle}} {{promo.promoDescription}}. {{$productOrderCtrl.translations['antibody.pdp.commerceCard.promotion.learnmore']}}
产品信息
17330-1-AP
种属反应
已发表种属
宿主/亚型
分类
类型
抗原
偶联物
形式
浓度
规格
纯化类型
保存液
内含物
保存条件
运输条件
产品详细信息
This antibody can recognize PGA3 (pepsinogen 3), PGA4(pepsinogen 4), PGA5(pepsinogen 5).
Immunogen sequence: MKWLLLLGL VALSECIMYK VPLIRKKSLR RTLSERGLLK DFLKKHNLNP ARKYFPQWEA PTLVDEQPLE NYLDMEYFGT IGIGTPAQDF TVVFDTGSSN LWVPSVYCSS LACTNHNRFN PEDSSTYQST SETVSITYGT GSMTGILGYD TVQVGGISDT NQIFGLSETE PGSFLYYAPF DGILGLAYPS ISSSGATPVF DNIWNQGLVS QDLFSVYLSA DDKSGSVVIF GGIDSSYYTG SLNWVPVTVE GYWQITVDSI TMNGETIACA EGCQAIVDTG TSLLTGPTSP IANIQSDIGA SENSDGDMVV SCSAISSLPD IVFTINGVQY PVPPSAYILQ SEGSCISGFQ GMNVPTESGE LWILGDVFIR QYFTVFDRAN NQVGLAPVA (1-388 aa encoded by BC029055 )
靶标信息
PGA5: Pepsinogen 5, group I (pepsinogen A). Pepsinogens are the inactive precursors of pepsin, the major acid protease found in the stomach. Pepsin is one of the main proteolytic enzymes secreted by the gastric mucosa. Pepsin consists of a single polypeptide chain and arises from its precursor, pepsinogen, by removal of a 41 amino acid segment from the N-terminus. Pepsinogen is synthesized in the stomach lining, and hydrochloric acid, also produced by the gastric mucosa, is necessary to convert the inactive enzyme and to maintain the optimum acidity (pH 1-3) for pepsin function. Pepsin is particularly effective in cleaving peptide bonds involving aromatic amino acids. Pepsin shows extremely broad specificity; although bonds involving phenylalanine and leucine are preferred, many others are also cleaved to some extent. PGA5 is a member of the subfamily A1 within the pepsin family and is the predominant endopeptidase in the gastric juice of vertebrates. PGA5 is inhibited by ovUS-1, a uterine serpin.
仅用于科研。不用于诊断过程。未经明确授权不得转售。
生物信息学
蛋白别名: pepsin A; Pepsin A-4; Pepsin A-5; Pepsin F; pepsinogen 5, group I; pepsinogen 5, group I (pepsinogen A); pepsinogen A5; pepsinogen F; pepsinogen F protein; Pepsinogen-4; Pepsinogen-5
基因别名: 1110035E17Rik; Pepf; Pg5; PGA5
UniProt ID: (Human) P0DJD9, (Mouse) Q9D106
Entrez Gene ID: (Human) 5222, (Mouse) 58803, (Rat) 60372